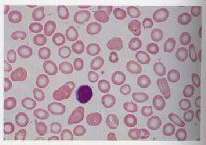
Signs of anaemia

What is - Anaemia
What are the different types of anaemia?
Anaemia can be classified by their causes and may be due to:
- reduced production of red cells
- increased red cell destruction or breakdown
- blood loss

Symptoms of Anaemia
What are the symptoms of anaemia?
Symptoms due to anaemia include:
Anaemia - Causes and Risk Factors
What causes of anemia?
Anaemia can arise from a range of causes, typically grouped into:
- Iron deficiency
- Folate and vitamin B12 deficiency
- Inflammation
- Bone marrow underproducing
- Malignant bone marrow disorders (e.g. myelodysplastic syndrome, leukemia, myelofibrosis)
- Increased red blood cell breakdown
- Thalassemia
Diagnosis of Anaemia
How is anaemia diagnosed?
Clinically, there are several laboratory tests that can assist the physicians to arrive at a diagnosis. A careful study of the blood film often offers many clues eg. changes in shape/size/colour of the blood cell, any abnormal intracellular inclusions, any parasites or worms present, etc. With these blood features as a guide, the clinician can proceed to other tests for diagnostic confirmation. These confirmatory tests may include a genetic study for certain hereditary disorders, biochemical determination of certain intracellular/extracellular chemical levels such as iron/folate, CT scan of the spleen for possible splenic disorders, bone marrow/lymph node biopsy for malignancies, etc.
Treatment for Anaemia
How is anaemia treated?
The treatment for anaemia is tailored to address its underlying cause. A haematologist will evaluate the patient to determine the specific cause of the anaemia and recommend appropriate treatment options. Depending on the diagnosis, the following treatments may be considered:
- Transfusion or red blood cells
- Infusions of iron
- Hormonal injections to boost red cell production
- Replacement of iron or vitamins and dietary advice
- Immunosuppressive medication to control an immune system that is destroying red blood cells
For anaemia due to blood cancers such as leukemias, myelomas, lymphomas or myelodysplastic syndrome, dedicated teams in the blood cancer service will assess and plan treatment with chemotherapy, immunotherapy or haematopoietic stem cell transplant as needed.
Anaemia - Other Information
Is anaemia that is caused by blood loss more life-threatening?
- It depends on the rate and volume of blood loss and the fitness of the individual. Sudden, rapid and ongoing blood loss can be life-threatening.
- If blood loss is slow and over a long period of time (eg. over a few months), the patient may not even experience any symptoms until the blood level has dropped considerably.
- Anaemia that causes a sudden rapid drop in red blood cells, such as haemolytic anaemia (red blood cell breakdown) can also be life threatening as there is no time for the body to compensate. There is no one cause of anaemia that is more life threatening than another. The cause needs to be identified early such that treatment can stop the blood loss and supportive transfusions can be given in the meantime.
How common is anaemia in Singapore?
- In a study (Sahadevan et al. 1995) of hospitalized patients above 65 years of age, about 1 in 3 patients (35.8%) were found to be anemic. More males (55.6%) than females (44.4%) have anaemia.
- In the younger age group, iron deficiency anaemia is more common in females than males. Iron deficiency anaemia in younger females is mainly due to excessive menstrual loss with inadequate iron replacement which may go untreated or undetected.
- Anaemia is a World Bank development indicator. In 2016, it was reported that 22% of non-pregnant women between the ages of 15-49 had anaemia in Singapore. Among pregnant women, 31% had anaemia.
Who are more prone to anaemia? Why?
- Causes of anaemia are wide ranging and there are several groups that are more prone to have anaemia. In women who have their menses, iron deficiency anaemia is common. In pregnant women, anaemia can occur due to dietary deficiencies and increased blood volume.
- In older patients with multiple medical problems or kidney disease, there is underproduction of red blood cells by the bone marrow due to inflammation, suppression, or lack of erythropoietin (which is a hormone produced by the kidneys to stimulate red blood cell production).
- Patients with malignancies may have anaemia due to the disease or due to medications that suppress the bone marrow.
- A common inherited anaemia in Singapore is thalassemia where abnormal production of haemoglobin results in anaemia. About 4% of our population are carriers of the thalassemia gene. A large proportion have thalassemia minor (thalassemia trait) with mild or undetectable anaemia and can lead a normal life. A small proportion have thalassemia major or intermedia that require blood transfusion. The risk of thalassemia major increases when both parents are carriers of the thalassemia gene. Therefore, screening is recommended for couples that are planning to start a family.
Contributed by
The information provided is not intended as medical advice. Terms of use. Information provided by SingHealth.
Condition Treated At
Department
Colorectal Surgery
Department
Obstetrics & Gynaecology
Department
Haematology
Get to know our doctors at SingHealth Hospitals in Singapore.
Get to know our doctors at SingHealth Hospitals in Singapore. here.





















 HealthXchange
HealthXchange
 Health Videos
Health Videos



